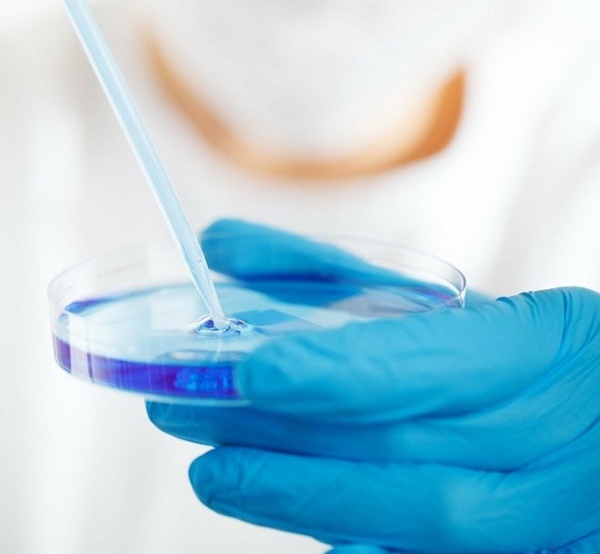

Recently Published Articles

Preventing Packaging Failures with HDPE Cards
Christian Packard
Regulations and Standards
— 2 minute read

Australia’s Unique Device Identification Framework
Beryl Choo
Regulations and Standards
Medical Device
— 3 minute read

How Medical Packaging Can Help Medical Device Manufacturers in Vietnam Win Tenders
Nurul Faiqah
Regulations and Standards
— 3 minute read
Contact Us
CONTACT US
CHAT